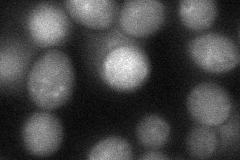
YLR396C
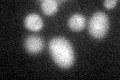
YLR396C
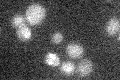
YLR396C

View description
ATP-binding protein that is a subunit of the HOPS complex and the CORVET tethering complex; essential for membrane docking and fusion at both the Golgi-to-endosome and endosome-to-vacuole stages of protein transport
Localization:
Intensity:
Fold change:
Significance:
-
C’ GFP library in SD

below threshold14.78 -
N' NOP1pr-GFP in SD

cytosol,punctate76.2605 -
N' TEF2pr-mCherry in SD

punctate,nucleus78.7606 -
N' NATIVEpr-GFP in SD

punctate35.9837 -
N' TEF2pr-VC and Cyto-VN in SD
cytosol,punctate48.4261 -
C’ GFP library in SD+DTT
cytosol14.130.95No -
C’ GFP library in SD+H2O2

cytosol15.281.03No -
C’ GFP library in Starvation Media
cytosol17.411.17No -
C’ GFP library on the background of Pup2-DaMP

below threshold -
C’ GFP library on the background of CCT mutant

below threshold14.12070.955004No
